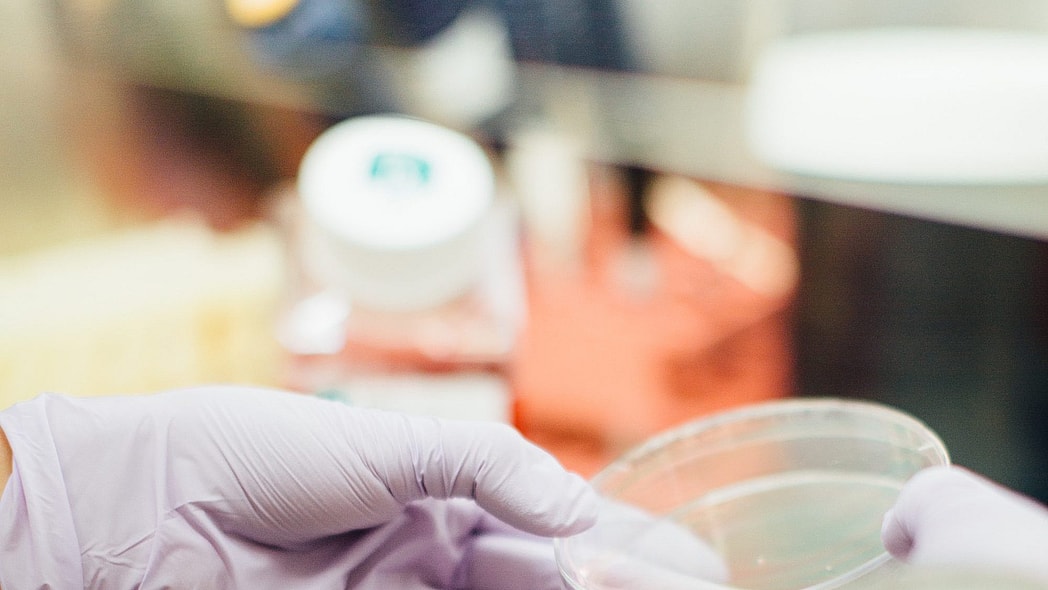

An observant customer of the popular brand Fashion Nova, blasted the brand for making a swim suit that could cause cancer. Twitter user, Twitter user @aziaani started the controversial claim when she took to the social media site to note the cancer warning tag on her new Fashion Nova swimsuit.
Fashion Nova has dominated the online retail space for the past year, made popular by influencers and celebrities such as Cardi B, Kim Kardashian and her little sister, Kylie Jenner. But, the brand has yet to respond to the sparked concern among some of its most loyal customers after this one tweet when viral, questioning if more of the garments may cause cancer, USA Today reports.
“This product can expose you to Di(2-ethylhexyl) phthalate, lead and cadmium, which are known to the state of California to cause cancer, birth defects, and other reproductive harm,” the tag reads.
Did y’all know this tag is in Fashion Nova swimsuits ? pic.twitter.com/pUK5S2BAMq
— azia ? (@aziaani_) April 29, 2019
Fans of the brand freaked out about this revelation, with many hitting up Twitter to share their reaction.
READ MORE: Cardi B and Fashion Nova teaming up for collaboration project
The brand was the most searched fashion term on Google in 2018, revelist.com reports and notes how several Black indie designers have slammed Fashion Nova for intentionally stealing their designs and selling the knockoffs at hella cheap prices. When they reach out to the company to address the matter, they are dismissed and oftentimes blocked on social media altogether, according to the report.
Most recently, Kardashian called out Fashion Nova via social media for knocking off the exclusives she receives from prominent designers and selling them items for hella cheap through its online store– this business model seems to be the California-based retailer’s claim to fame.
It’s devastating to see these fashion companies rip off designs that have taken the blood, sweat and tears of true designers who have put their all into their own original ideas.
— Kim Kardashian West (@KimKardashian) February 19, 2019
The state requires that the cancer warning labels are placed on hotels, alcohol, coffee and clothes. Fashion Nova promotes its garments 24/7 on Instagram.
When @Aziaani posted a photo on Twitter of her new neon green bathing suit with the cancer warning tag, she asked her followers, “Did y’all know this tag is in Fashion Nova swimsuits?”
Her post was retweeted more than 5,000 times and liked by more than 7,000 people.
“You get what you paid for,” said Twitter user @bxfantasi.
You get what you paid for.
— ᴘᴀᴛᴇɴᴛ ʟᴇᴀᴛʜᴇʀ (@bxfANTaSi) April 30, 2019
“They’re not getting any more of my coins,” @Aziaani replied.
At the time of this post, the $34.99 Water Sports Bikini at the center of the cancer-tag debate was sold out on Fashion Nova’s website. It has a 5-star rating and 75 reviews.
This on a lot of they clothes y’all love wearing and I seen so many girls with this bathing suit ?? https://t.co/X2AAPxV4kB
— Nya ???♀️ (@BufordNya) April 29, 2019